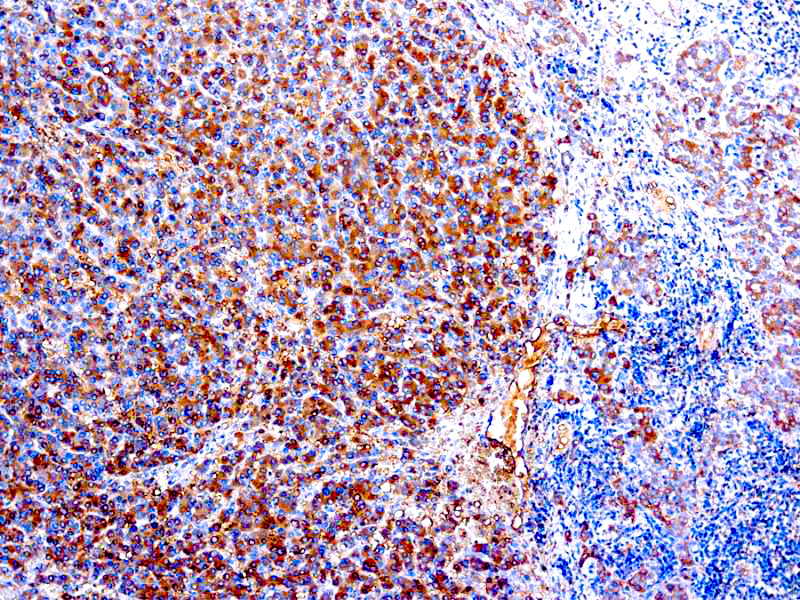

The antibody isspecific against human α-1-antitrypsin. This antibody stains macrophages in human tissues and does not stain any other cell type.
Alpha (α )-1-Antitrypsin
SKU: 8560
Categories: Primary Antibodies, IVD - For U.S. Market, IVD - Outside U.S. Market
Tags: A, Highlighter Product, HL72K-Core Kit, Concentrated
Description
Additional information
| Catalog No. | PDR021, PDR021-HL, RP048 |
|---|---|
| Clone | Rabbit |
| Intended Use | IVD |
| Immunogen | α-1-antitrypsin isolated from human serum. |
| Species | Rabbit |
| Cellular Localization | Cytoplasmic |
| Positive Control Tissue | Tonsil |
| Pretreatment | None |
| Incubation & Temperature | 30 min @ RT |
| Detection System | PolyVue™ Plus – Two Step Detection System or Montage PolyVue Plus™ Auto Detection System for Montage 360 System or HighLighter core kit for HighLighter Staining System |
| Description/Type | Rabbit Polyclonal Antibody |
| Format | Purified immunoglobulin fraction of rabbit antiserum against alpha-1-antitrypsin containing sodium azide as a preservative. |
DATASHEETS & SDS
DATASHEETS & SDS
| Download Datasheet |
| Download SDS Sheet – OSHA |
REFERENCES
REFERENCES
- Clausen et al. Acta Path Microbiol Sect A 88: 299,1980.
- Ka!shaker et al. Alic Chim Acta 148; 157, 1985.
- Krugliak et al. Am 1Hematol 21: 99, 1982.
Reviews (0)
Only logged in customers who have purchased this product may leave a review.

Reviews
There are no reviews yet.